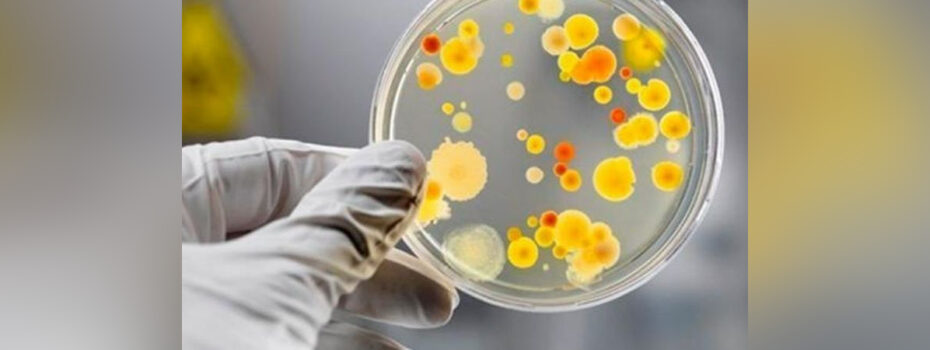

Сало вважають традиційним продуктом української кухні, що має багатовікову історію. Його споживали ще давні слов’яни, воно символізувало достаток і довгий час залишалося важливим запасом їжі завдяки можливості тривалого зберігання без холодильника. Повідомили Вінницький обласний центр контролю та профілактики хвороб МОЗ України У День українського сала лікарка з загальної гігієни Світлана Савич розповіла про особливості цього […]
21–22 серпня у Вінницькій області відбулися моніторингові візити кабінетів замісної підтримувальної терапії для пацієнтів з опіоїдною залежністю. Перевірку проводили представники Центру громадського здоров’я МОЗ України та Всеукраїнського об’єднання людей з наркозалежністю «VOLNa». Повідомили Всеукраїнське об’єднання людей з наркозалежністю НемирівУ КНП «Немирівська ЦРЛ» виявлено критичну ситуацію: лікар, який вів програму ПТАО, залишив посаду. Через це 27 […]
У період із 1 червня по 1 жовтня 2025 року в Україні триває посилений епідеміологічний нагляд за холерою у зв’язку з підвищеним ризиком поширення кишкових інфекцій. Повідомили Вінницький обласний центр контролю та профілактики хвороб МОЗ України За 34-й тиждень у Вінницькій області зареєстровано 87 випадків захворювань на гострі кишкові інфекції. Лабораторних обстежень людей на холеру […]
Відповідно до плану роботи на вересень 2025 року пересувний мамограф «Квітка» Подільського регіонального центру онкології здійснить виїзди у громади області. Зокрема, 4–5 вересня мобільний мамограф працюватиме у місті Погребище. Повідомили Подільський регіональний центр онкології – ПРЦО Обстеження є безоплатним за наявності е-направлення від сімейного або лікуючого лікаря (код: 59300-00 – рентгенографія молочної залози, двобічна). Основні […]
Центр громадського здоров’я нагадує рекомендації щодо організації зручного та безпечного навчального простору для дітей напередодні нового навчального року. Повідомили Вінницький обласний центр контролю та профілактики хвороб МОЗ України Вибір меблів:Робоче місце школяра має включати письмовий стіл та стілець, підібрані відповідно до зросту дитини. При правильній посадці: Освітлення:Під час денного навчання слід використовувати природне світло без […]
Протягом останнього десятиліття в Україні зафіксовано зростання кількості випадків психічних розладів серед дітей та підлітків. За даними 2024 року, у віковій групі 0–14 років діагностовано 105 280 випадків розладів психіки та поведінки, у групі 15–17 років — 25 654 випадки. Це на 17% більше порівняно з 2022 роком. Повідомили Вінницький обласний центр контролю та профілактики […]
За результатами щоденного моніторингу радіаційного фону у контрольних точках Вінницької області, показники залишаються стабільними та відповідають багаторічним рівням місцевості. Повідомили Вінницький обласний центр контролю та профілактики хвороб МОЗ України У Вінницькому районі рівень становить 0,12 мкЗв/год, що знаходиться в межах норми. Для порівняння, у інших районах області зафіксовано такі показники: Усі результати відповідають природному фону […]
Лікар функціональної реабілітації Юрій Лукашенко та фізичний терапевт Руслан Бойчук з реабілітаційного відділення КНП «Немирівська міська лікарня» ознайомлюються з новітніми методами лікування, які застосовуються у світовій практиці. Повідомили Немирівська міська лікарня Нещодавно вони взяли участь у заході, організованому професором Максом Ортіс Каталаном, доцентом Інституту біороботики Scula Superiore Sant`Anna (м. Піза, Італія). Під час навчання спеціалісти […]
18–19 серпня у смт Оратів, біля приміщення амбулаторії загальної практики – сімейної медицини, працюватиме мамограф «Квітка» комунального некомерційного підприємства «Подільський регіональний центр онкології Вінницької обласної Ради». Плвідомили Оратівська селищна територіальна громада Захід проводиться відповідно до наказу Міністерства охорони здоров’я України від 5 серпня 2024 року № 1368 «Про забезпечення скринінгу і ранньої діагностики окремих видів […]
У Вінницькій області продовжують фіксувати перевищення гранично допустимих концентрацій (ГДК) шкідливих речовин в атмосферному повітрі. Дані оприлюднили у Вінницькому обласному центрі контролю та профілактики хвороб. Повідомили Вінницький обласний центр контролю та профілактики хвороб МОЗ України У 2024 році лабораторії Центру дослідили 14 408 проб атмосферного повітря у 147 населених пунктах області, з яких 90 — […]